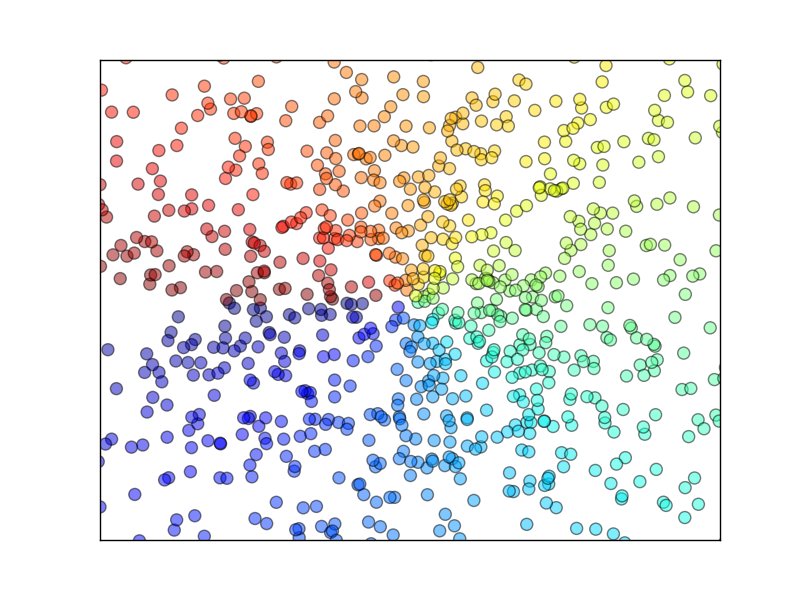

Matplotlib
(Chrome无法播放优酷? 网址框输入"chrome://settings/content/", 勾选允许 Flash Player. 实在不行? 请 点击这里)
Scatter 散点图
作者: Hao 编辑: 莫烦 2016-11-03
学习资料:
本节我们将讲述各种不同的plot的方式。之前我们讲到了如何plot线,今天我们讲述如何plot散点图。 今天用到的例子最终呈现的结果如下图:
散点图
首先,先引入matplotlib.pyplot简写作plt,再引入模块numpy用来产生一些随机数据。生成1024个呈标准正态分布的二维数据组 (平均数是0,方差为1) 作为一个数据集,并图像化这个数据集。每一个点的颜色值用T来表示:
import matplotlib.pyplot as plt
import numpy as np
n = 1024 # data size
X = np.random.normal(0, 1, n) # 每一个点的X值
Y = np.random.normal(0, 1, n) # 每一个点的Y值
T = np.arctan2(Y,X) # for color value
数据集生成完毕,现在来用scatterplot这个点集,鼠标点上去,可以看到这个函数的各个parameter的描述,如下图:

输入X和Y作为location,size=75,颜色为T,color map用默认值,透明度alpha 为 50%。
x轴显示范围定位(-1.5,1.5),并用xtick()函数来隐藏x坐标轴,y轴同理:
plt.scatter(X, Y, s=75, c=T, alpha=.5)
plt.xlim(-1.5, 1.5)
plt.xticks(()) # ignore xticks
plt.ylim(-1.5, 1.5)
plt.yticks(()) # ignore yticks
plt.show()
这些就是本节内容,下节我们将介绍怎么运用条形图bar。
莫烦Python